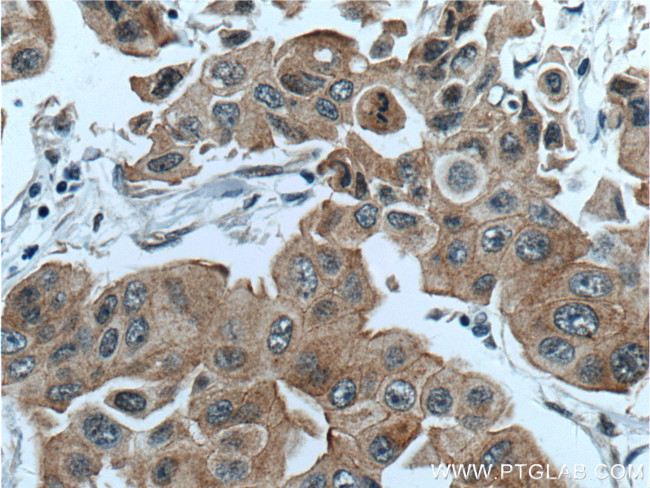
PPP1R13L Antibody in Immunohistochemistry (Paraffin) (IHC (P))

Search
Proteintech
PPP1R13L Polyclonal Antibody
{{$productOrderCtrl.translations['antibody.pdp.commerceCard.promotion.promotions']}}
{{$productOrderCtrl.translations['antibody.pdp.commerceCard.promotion.viewpromo']}}
{{$productOrderCtrl.translations['antibody.pdp.commerceCard.promotion.promocode']}}: {{promo.promoCode}} {{promo.promoTitle}} {{promo.promoDescription}}. {{$productOrderCtrl.translations['antibody.pdp.commerceCard.promotion.learnmore']}}
产品信息
51141-1-AP
种属反应
宿主/亚型
分类
类型
抗原
偶联物
形式
浓度
规格
纯化类型
保存液
内含物
保存条件
运输条件
产品详细信息
Immunogen sequence: MDSEAFQSA RDFLDMNFQS LAMKHMDLKQ MELDTAAAKV DELTKQLESL WSDSPAPPGP QAGPPSRPPR YSSSSIPEPF GSRGSPRKAA TDGADTPFGR SESAPTLHPY SPLSPKGRPS SPRTPLYLQP DAYGSLDRAT SPRPRAFDGA GSSLGRAPSP RPGPGPLRQQ GPPTPFDFLG RAGSPRGSPL AEGPQAFFPE RGPSPRPPAT AYDAPASAFG SSLLGSGGSA FAPPLRAQDD L (1-240 aa encoded by BC032298)
靶标信息
IASPP is one of the most evolutionarily conserved inhibitors of p53 (TP53), whereas ASPP1. and ASPP2. are activators of p53.
仅用于科研。不用于诊断过程。未经明确授权不得转售。
生物信息学
蛋白别名: inhibitor of apoptosis stimulating protein of p53; Inhibitor of ASPP protein; NFkB interacting protein 1; NFkB-interacting protein 1; NKIP1; PPP1R13B-like protein; ppp1r13l; Protein iASPP; protein phosphatase 1, regulatory (inhibitor) subunit 13 like; RelA-associated inhibitor; retinoic acid induced 4; unnamed protein product
基因别名: ARCME; AV260376; CMAEA; IASPP; NKIP1; PPP1R13BL; PPP1R13L; RAI; RAI4; wa3
UniProt ID: (Human) Q8WUF5, (Mouse) Q5I1X5
Entrez Gene ID: (Human) 10848, (Mouse) 333654